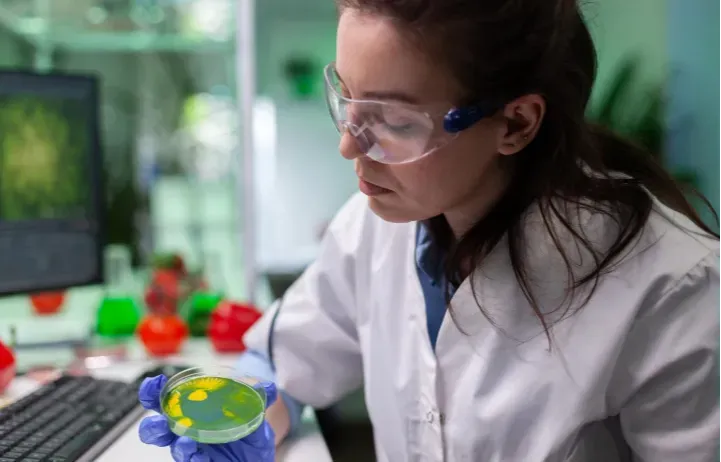
Entzündungen LOSWERDEN und Arterien schützen!

Ohne Zuckerzusatz aber trotzdem mit Zucker?!
Hast du dich auch schon mal gefragt, ob das, was gesund aussieht, wirklich so gesund ist? Fitnessriegel, Fruchtsäfte oder Super-Bowl – viele Produkte in unseren geliebten Supermärkten wirken auf den ersten Blick wie eine gesunde Wahl. Schließlich steht da „ohne Zuckerzusatz“, „reich an Vitaminen“ oder „100 % natürlich“ auf der Verpackung. Klingt doch gut, oder?